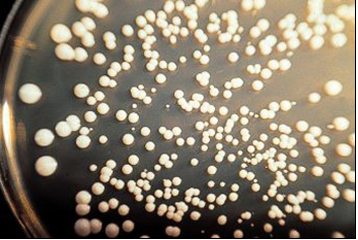
Sacharomyces cerevisiae

YGC CHLORAMPHENICOL GLUCOSE AGAR (Y.G.C.)
Agar para recuento de hongos (levaduras y mohos) en lácteos y otros productos
AGAR AL EXTRACTO DE LEVADURA, DEXTROSA Y CLORANFENICOL
Detección y recuento de Levaduras y Mohos en productos lácteos (UNE 34-821:1986, ISO 7954:1987) y otros.
COMPOSICIÓN
Extracto de levadura 5.00 g
Glucosa 20.00 g
Cloranfenicol 0,10 g
Agar-agar 15.00 g
(Fórmula por litro)
pH final: 6.6 ± 0,2
PARA USO EXCLUSIVO EN LABORATORIO
MANTENGA EL BOTE BIEN CERRADO EN LUGAR SECO, FRESCO Y OSCURO.
AGITE EL BOTE ANTES DE USAR.
PREPARACIÓN
Disolver 40’1 gramos de medio en 1 litro de agua bidestilada. Calentar, agitando, hasta ebullición, para la total homogeneización. Repartir en tubos o en frascos. Autoclavar a 121 ºC durante 15 minutos, o mejor a 116 ºC durante 10 minutos. El color final del medio es crema. Evitar todo sobrecalentamiento que pueda caramelizar la glucosa (medio ámbar).
PRESENTACION: MEDIO DESHIDRATADO CODIGO: DMT155, TUBOS PREPARADOS CÓDIGO TPL022
CONTROL DE CALIDAD DEL MEDIO:
Realizado en nuestro laboratorio; es prudente repetirlo en su laboratorio siempre que varíen las condiciones (más de 3 meses sin usar, tras desinfectar laboratorio, tras conservar a alta Tª, cuando adquiere aspectos extraños aunque no haya llegado la fecha de caducidad teórica de la etiqueta,…)
DESHIDRATADO: Polvo grueso, Crema
PREPARADO: Estéril, Crema
CONTROL DE CRECIMIENTO CUANTITATIVO 3-5 días a temperatura ambiente (21-28°C aproximadamente):
- Aspergillus niger MKTA 16404, Correcto, Colonias negras y esporuladas en 5 días. Con respecto a SDA estandarizado*, recuento medio 95%, pero de forma selectiva.
- Candida albicans MKTA 10231, Excelente. Con respecto a SDA estandarizado*, recuento 133-140 %, pero de forma selectiva.
- Saccharomyces cerevisiae MKTA 9763, Correcto. Con respecto a SDA estandarizado*, recuento medio 95 %, pero de forma selectiva.
- Staphylococcus aureus MKTA 6538P, Inhibido completamente.
- E. coli MKTA 25922, Inhibido completamente.
* El que cumple con recuperación superior al 92-125% con respecto a cepas cuantitativas trazables a la cepa tipo.
SIEMBRA E INTERPRETACIÓN
Los mohos flotan: Agitar la solución madre justo antes de tomar la alícuota. Sembrar en superficie 0.1ml de la muestra y su serie de diluciones decimales, repartiendo con asa de Digralsky (VRR154, VLC155) (y mejor un duplicado en masa para mejor sensibilidad de levaduras). Incubar 3-5 días a 21-25 ºC aproximadamente. Medio para recuento rápido de levaduras y mohos que obtiene recuperaciones excelentes con respecto al Sabouraud Dextrose Agar.
El usuario es el único responsable de la eliminación de los microorganismos según la legislación medioambiental vigente. Autoclavar antes de desechar a la basura.
Si desea más información sobre nuestros MEDIO CHLORAMPHENICOL GLUCOSE AGAR (YGC) rellene nuestro formulario de contacto http://www.medioscultivo.com/contacto . O si lo prefiere póngase en contacto con nosotros a través de nuestro correo electrónico microkit@microkit.es o por teléfono en el nº 91-897 46 16
https://www.microkit.es/fichas/CHLORAMPHENICOL-GLUCOSE-AGAR-YGC.pdf
Si lo que desea es una mayor biomasa y esporulación de sus mohos, use Potato Dextrose Agar:
https://www.microkit.es/fichas/POTATO-DEXTROSE-AGAR.pdf
Si prefiere un recuento más cercano a la realidad, máximo, emplee DRBC Agar:
https://www.microkit.es/fichas/DICLORAN-ROSA-BENGALA-CLORANFENICOL-AGAR.pdf
Y si lo que necesita es obtener resultados mas rápidos en la detección y recuento de hongos (levaduras y mohos) en tonces su medio es el Rapid YM Agar:
https://www.microkit.es/fichas-tecnicas-medios-de-cultivo.htm
https://www.microkit.es/monograficos/4-Levaduras-y-mohos-monograf–a.pdf

DESEO MÁS INFORMACIÓN DEL MEDIO Y.G.C. Y EL COSTO DEL MISMO SU PRESENTACIÓN.
Buenos días
Respondemos a su consulta desde nuestro correo general.
Muchas gracias por visitar nuestro blog y contactar con nosotros. Un cordial saludo
MAS INFORMACIÓN DEL COSTO
Buenos días
Respondemos a su consulta desde nuestro correo general.
Muchas gracias por visitar nuestro blog y contactar con nosotros. Un cordial saludo
Deseo obtener más información sobre este medio de cultivo CHLORAMPHENICOL GLUCOSE AGAR (Y.G.C.)
Buenos días,
Respondemos su consulta desde nuestro correo general. Muchas gracias por visitar nuestro blog y contactar con nosotros.
Un cordial saludo